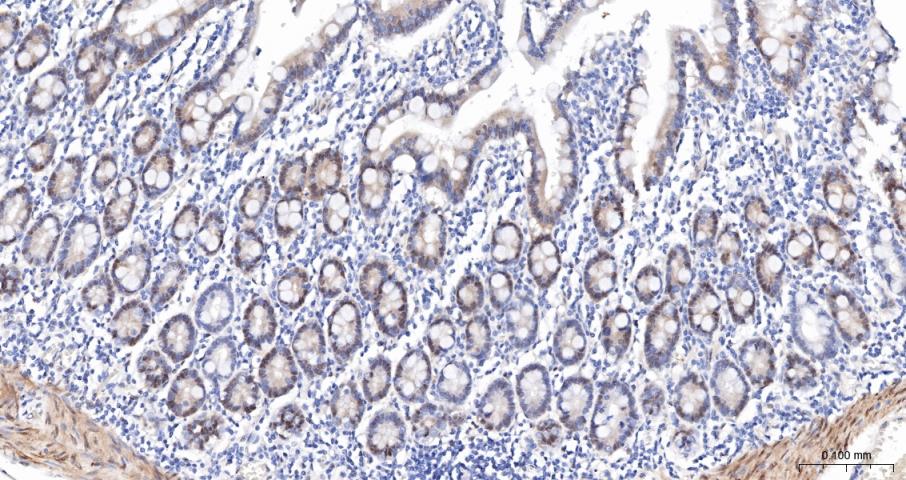
磷酸化原癌基因Yes相关蛋白1重组兔单抗
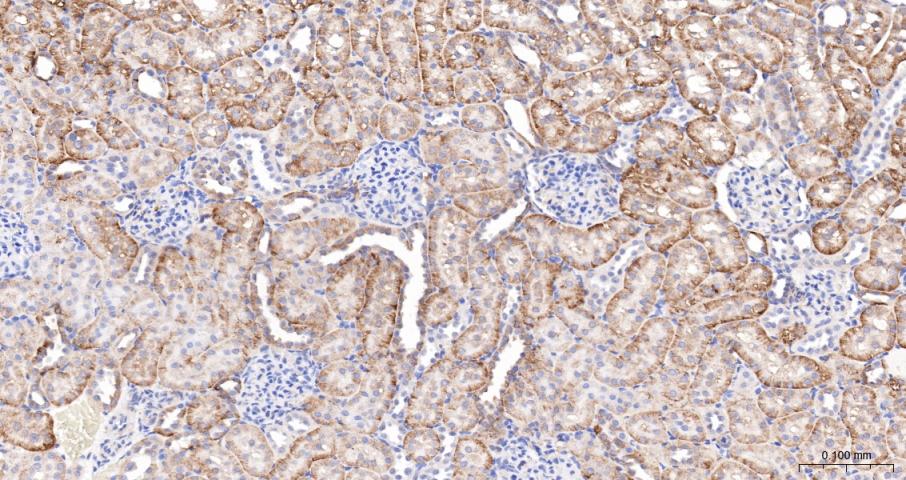
磷酸化原癌基因Yes相关蛋白1重组兔单抗

phospho-YAP1 (Ser127) Recombinant Rabbit mAb (一抗) - WB,IHC-P,IHC-F,IF | Bioss
Rrmab?兔单抗

货号:bsm-52214R
产品详情
相关标记
相关产品
相关文献
常见问题
概述
产品编号
bsm-52214R
产品类型
磷酸化抗体、重组兔单抗
英文名称
phospho-YAP1 (Ser127) Recombinant Rabbit mAb
中文名称
磷酸化原癌基因Yes相关蛋白1重组兔单抗
英文别名
YAP1 (phospho-S127); p-YAP1; phospho-YAP1; YAP1 (phospho-Ser127); COB1; YAP; YAP-1; YAP2; YAP65; YKI; YAP1_HUMAN; YAP1; Yes-associated protein 1; Protein yorkie homolog; Yes-associated protein YAP65 homolog;
抗体来源
Rabbit
免疫原
A synthesized peptide derived from human YAP1 around the phosphorylation site of S127: AH-pS-SP
亚型
IgG
性状
Liquid
纯化方法
affinity purified by Protein A
克隆类型
Recombinant
克隆号
1H12
理论分子量
55 kDa
检测分子量
65 kDa
浓度
1mg/ml
储存液
0.01M TBS (pH7.4) with 1% BSA, 0.02% Proclin300 and 50% Glycerol.
研究领域
SWISS
Gene ID
保存条件
Shipped at 4℃. Store at -20℃ for one year. Avoid repeated freeze/thaw cycles.
注意事项
This product as supplied is intended for research use only, not for use in human, therapeutic or diagnostic applications.
背景资料
This gene encodes the human ortholog of chicken YAP protein which binds to the SH3 domain of the Yes proto-oncogene product. This protein contains a WW domain that is found in various structural, regulatory and signaling molecules in yeast, nematode, and mammals, and may be involved in protein-protein interaction. [provided by RefSeq].

产品应用
| 应用 | 已检合格种属 | 预测种属 | 推荐稀释比例 |
|---|---|---|---|
| WB | Human, Mouse | Rat | 1:500-5000 |
| IHC-P | Human, Mouse, Rat | 1:100-500 | |
| IHC-F | Human, Mouse, Rat | 1:100-500 | |
| IF | Human, Mouse, Rat | 1:100-500 |
交叉反应
交叉反应: Human, Mouse, Rat
相关产品
暂无相关产品
靶标
基因名
YAP1
蛋白名
Transcriptional coactivator YAP1
亚基
Binds to the SH3 domain of the YES kinase. Binds to WBP1 and WBP2. Binds, in vitro, through the WW1 domain, to neural isoforms of ENAH that contain the PPSY motif (By similarity). The phosphorylated form interacts with YWHAB. Interacts (via WW domains) with LATS1 (via PPxY motif 2). Interacts with LATS2. Isoform 2 and isoform 3 interact (via WW domain 1) with isoform 3 of ERBB4 (via PPxY motif 2). Interacts with TEAD1, TEAD2, TEAD3 and TEAD4. Interacts with TP73. Interacts with RUNX1. Interacts with HCK.
亚细胞定位
Cytoplasm. Nucleus.
组织特异性
Increased expression seen in some liver and prostate cancers. Isoforms lacking the transactivation domain found in striatal neurons of patients with Huntington disease (at protein level).
翻译后修饰
Phosphorylated by LATS1 and LATS2; leading to cytoplasmic translocation and inactivation. Phosphorylated by ABL1; leading to YAP1 stabilization, enhanced interaction with TP73 and recruitment onto proapoptotic genes; in response to DNA damage.
相似性
Belongs to the YORKIE family.
Contains 2 WW domains.
Contains 2 WW domains.
功能
Transcriptional regulator which can act both as a coactivator and a corepressor and is the critical downstream regulatory target in the Hippo signaling pathway that plays a pivotal role in organ size control and tumor suppression by restricting proliferation and promoting apoptosis (PubMed:17974916, PubMed:18280240, PubMed:18579750, PubMed:21364637). The core of this pathway is composed of a kinase cascade wherein STK3/MST2 and STK4/MST1, in complex with its regulatory protein SAV1, phosphorylates and activates LATS1/2 in complex with its regulatory protein MOB1, which in turn phosphorylates and inactivates YAP1 oncoprotein and WWTR1/TAZ (PubMed:18158288). Plays a key role in tissue tension and 3D tissue shape by regulating cortical actomyosin network formation. Acts via ARHGAP18, a Rho GTPase activating protein that suppresses F-actin polymerization (PubMed:25778702). Plays a key role to control cell proliferation in response to cell contact. Phosphorylation of YAP1 by LATS1/2 inhibits its translocation into the nucleus to regulate cellular genes important for cell proliferation, cell death, and cell migration (PubMed:18158288). The presence of TEAD transcription factors are required for it to stimulate gene expression, cell growth, anchorage-independent growth, and epithelial mesenchymal transition (EMT) induction.
Isoform 2: Isoform 2 and isoform 3 can activate the C-terminal fragment (CTF) of ERBB4 (isoform 3).
Isoform 2: Isoform 2 and isoform 3 can activate the C-terminal fragment (CTF) of ERBB4 (isoform 3).
同靶标产品
相关文献
提示: 发表研究结果有使用 bsm-52214R 时请让我们知道,以便我们可以引用参考文章。作为回馈,资料提供者将获得我们送上的小礼品。
具体参考文献:bsm-52214R 被引用于7文献中